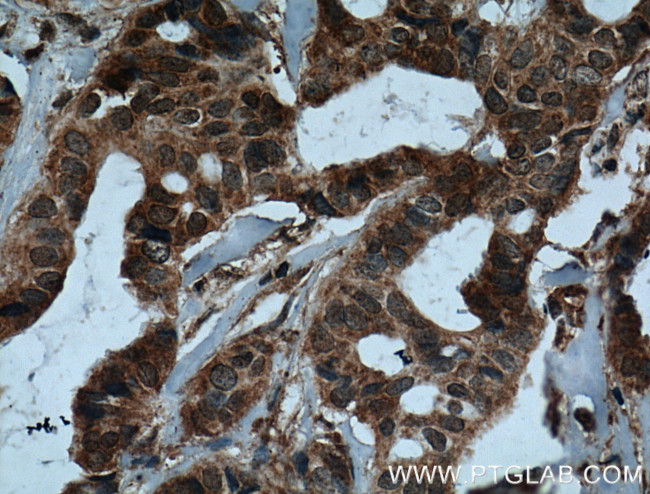
IL37 Antibody in Immunohistochemistry (Paraffin) (IHC (P))
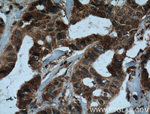
IL37 Antibody in Immunohistochemistry (Paraffin) (IHC (P))
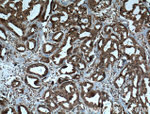
IL37 Antibody in Immunohistochemistry (Paraffin) (IHC (P))

Search
Proteintech
IL37 Monoclonal Antibody (7F1A1)
{{$productOrderCtrl.translations['antibody.pdp.commerceCard.promotion.promotions']}}
{{$productOrderCtrl.translations['antibody.pdp.commerceCard.promotion.viewpromo']}}
{{$productOrderCtrl.translations['antibody.pdp.commerceCard.promotion.promocode']}}: {{promo.promoCode}} {{promo.promoTitle}} {{promo.promoDescription}}. {{$productOrderCtrl.translations['antibody.pdp.commerceCard.promotion.learnmore']}}
产品信息
60296-1-IG
种属反应
已发表种属
宿主/亚型
分类
类型
克隆号
抗原
偶联物
形式
浓度
纯化类型
保存液
内含物
保存条件
运输条件
产品详细信息
Immunogen sequence: MSFVGENSG VKMGSEDWEK DEPQCCLEDP AVSPLEPGPS LPAMNFVHTS PKVKNLNPKK FSIHDQDHKV LVLDSGNLIA VPDKNYIRPE IFFALASSLS SASAEKGSPI LLGVSKGEFC LYCDKDKGQS HPSLQLKKEK LMKLAAQKES ARRPFIFYRA QVGSWNMLES AAHPGWFICT SCNCNEPVGV TDKFENRKHI EFSFQPVCKA EMSPSEVSD (1-218 aa encoded by BC020637 )
靶标信息
The protein encoded by this gene is a member of the interleukin 1 cytokine family. This cytokine can bind to, and may be a ligand for interleukin 18 receptor (IL18R1/IL-1Rrp). This cytokine also binds to interleukin 18 binding protein (IL18BP), an inhibitory binding protein of interleukin 18 (IL18), and subsequently forms a complex with IL18 receptor beta subunit, and through which it inhibits the activity of IL18. This gene along with eight other interleukin 1 family genes form a cytokine gene cluster on chromosome 2. Five alternatively spliced transcript variants encoding distinct isoforms have been reported.
仅用于科研。不用于诊断过程。未经明确授权不得转售。
生物信息学
蛋白别名: FIL1 zeta; IL-1 zeta; IL-1F7; IL-1F7b (IL-1H4, IL-1H, IL-1RP1); IL-1H; IL-1RP1; IL-1X; IL-1X protein; IL-37; IL1F7 (canonical product IL-1F7b); ILN; Interleukin; interleukin 1 family member 7; interleukin 1, zeta; Interleukin-1 family member 7; Interleukin-1 homolog 4; interleukin-1 superfamily z; Interleukin-1 zeta; Interleukin-1-related protein; interleukin-23; Interleukin-37; Interleukin37
基因别名: FIL1; FIL1(ZETA); FIL1Z; IL-1F7; IL-1H; IL-1H4; IL-1RP1; IL-37; IL1F7; IL1H4; IL1RP1; IL37
UniProt ID: (Human) Q9NZH6
Entrez Gene ID: (Human) 27178